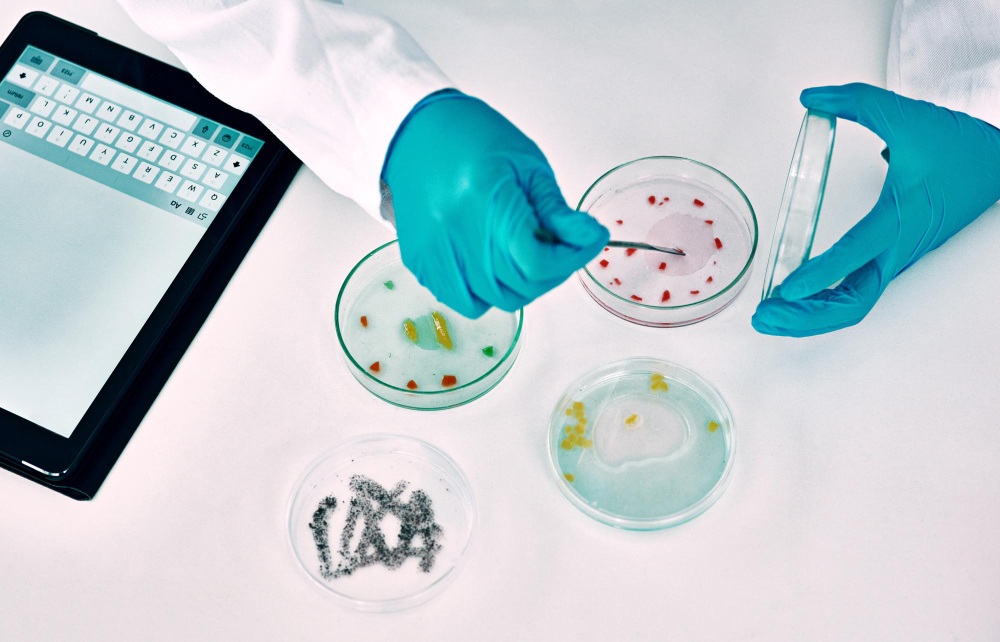
Buyer’s Guide – Choosing EM Vendors, Media, Samplers & Software In The Pharmaceutical Microbiology Industry

by Mrudula Kulkarni
7 minutes
Buyer’s Guide – Choosing EM Vendors, Media, Samplers & Software In The Pharmaceutical Microbiology Industry
A complete buyer’s guide for choosing EM vendors, media, air samplers, and software in pharma microbiology to ensure compliance and reliability.
Environmental monitoring (EM) is the backbone of microbiological quality control in pharmaceutical manufacturing. In cleanrooms where sterile injectables, biologics, or critical drug formulations are produced, the tiniest lapse in microbial control can lead to contamination, regulatory observations, or even product recalls.
Because of this, pharmaceutical companies invest heavily in EM programs that combine culture media, microbial air samplers, particle counters, and specialized software to ensure compliance with global standards such as FDA, EMA, MHRA, and WHO guidelines.
Understanding the principles of active air vs settle vs contact plates is crucial for selecting the right air monitoring methods that complement your vendor’s EM systems.
But here’s the challenge: the market is flooded with EM solutions. There are multiple vendors offering culture media, automated samplers, and software platforms, each promising compliance, efficiency, and cost savings.
For decision-makers in quality assurance (QA) and microbiology, choosing the right vendor is not just about pricing. It is about reliability, regulatory alignment, service support, and long-term scalability.
This buyer’s guide will help you navigate the selection process for EM vendors, media, samplers, and software in the pharmaceutical microbiology industry, ensuring that your cleanroom monitoring program is both regulatory compliant and operationally sustainable.
Why Vendor Selection Matters In Environmental Monitoring
The pharmaceutical microbiology industry is unlike any other. Here, the cost of a poor vendor choice is not just financial; it directly affects patient safety and regulatory approval.
A supplier who cannot consistently deliver sterile contact plates, who provides unreliable microbial samplers, or whose EM software lacks data integrity controls can put your entire GMP compliance at risk.
Regularly assessing alert and action levels in cleanroom monitoring ensures your selected vendors maintain the same compliance standards expected during audits.
Moreover, regulatory authorities are increasingly scrutinizing not just the drug manufacturer but also its vendors. Supplier qualification audits, documentation reviews, and proof of GMP-compliant supply chains are mandatory.
In short, vendor selection is part of your compliance ecosystem. Choosing wisely reduces risk, while cutting corners can prove costly.
Key Considerations for Choosing EM Vendors
When assessing potential vendors for environmental monitoring solutions, pharmaceutical companies should carefully evaluate several factors:
- Regulatory Compliance & Certifications – Vendors must comply with ISO standards, pharmacopeial requirements (USP, EP, JP), and cGMP guidelines. Ask for evidence of sterility assurance, growth promotion test validation, and stability studies for media.
- Supply Chain Security – Delays or inconsistencies in supply can disrupt monitoring schedules. Ensure that vendors have reliable distribution networks and contingency plans for emergencies.
- Customization & Flexibility – Every facility has unique requirements based on cleanroom grade, process flow, and regulatory expectations. A strong vendor will customize media formulations, sampler accessories, or reporting tools to meet your needs.
- Technical & Training Support – The best vendors don’t just sell products; they provide training, troubleshooting, and validation support. This is especially critical for implementing EM software or calibrating air samplers.
- Global Footprint vs. Local Presence – A multinational vendor may bring global best practices, but local distributors often ensure faster deliveries and on-site technical support. Ideally, choose a partner with both capabilities.
Selecting The Right Media For Environmental Monitoring
Media is the heart of microbial monitoring. Contact plates, settle plates, and broth media detect microbial contamination on surfaces, in the air, and during personnel monitoring. But not all media is created equal. Buyers should focus on the following aspects:
Pre-filled vs. In-house Prepared Media
Pharmaceutical companies often debate whether to prepare media in-house or purchase pre-filled plates. Pre-filled plates from qualified vendors offer consistent quality, validated sterility, and reduced labor costs. In contrast, in-house preparation can introduce variability and requires additional QC resources.
Media Formulations
Different monitoring needs require specific formulations:
- Tryptic Soy Agar (TSA): Widely used for surface and air monitoring.
- Sabouraud Dextrose Agar (SDA): Selective for fungi and yeasts.
- Neutralizers (Lecithin, Polysorbate 80): Added to TSA for disinfectant-neutralizing purposes.
Selecting a vendor who provides validated formulations with robust growth promotion test data is critical. The media must be proven to recover stressed or low-level microorganisms commonly found in cleanrooms.
Shelf Life & Storage Conditions
An extended shelf life reduces inventory challenges. Vendors offering gamma-irradiated plates with longer expiry dates provide more flexibility. Always check vendor data on media stability under refrigeration.
Packaging & Handling
Look for double or triple-wrapped sterile packaging to maintain aseptic integrity during transfer into cleanrooms. Vendors with smart packaging solutions reduce handling risks.
Choosing Microbial Air Samplers
Air monitoring is one of the most sensitive aspects of EM. Regulators expect companies to perform routine viable air monitoring using microbial air samplers that comply with ISO 14698 and GMP Annex 1 requirements.
The USP <1116> alert and action levels provide detailed guidance for interpreting microbial air sampler data and setting appropriate thresholds. Choosing the right sampler involves looking at both technical specifications and usability.
Types of Samplers
- Impaction Samplers: Use airflow to impact microorganisms onto agar plates (e.g., sieve samplers). Widely used in pharma cleanrooms.
- Liquid-based Samplers: Capture microorganisms into liquid media for further analysis.
- Active vs. Passive Sampling: Active samplers pull a fixed volume of air, while settle plates (passive) capture microbes by sedimentation. Active sampling provides more reliable quantitative data.
Performance Factors
When comparing vendors, pay close attention to:
- Airflow Rate: Typically 100–200 liters/min; higher flow reduces sampling time.
- Accuracy & Reproducibility: Must demonstrate consistent recovery in validation studies.
- Portability: Lightweight, easy-to-handle samplers improve compliance during monitoring.
- Battery Life & Charging: Long-lasting batteries support full-shift operations.
- Ease of Cleaning: GMP requires samplers to be easily disinfected without leaving residues.
Vendor Support
The sampler is not a one-time purchase; it requires calibration, spare parts, and sometimes software integration. Choose a vendor with a strong service network and traceable calibration protocols.
EM Software: The Digital Backbone Of Compliance
With increasing focus on data integrity (ALCOA+ principles), EM software has become indispensable for pharmaceutical microbiology labs. As part of data integrity, it’s essential to establish alert levels for cleanroom monitoring, an approach detailed in the USP 1116 Alert & Action Levels for Cleanrooms.
Paper-based EM logs are prone to errors, missing data, and compliance risks. Modern EM software platforms automate data collection, trending, reporting, and audit trail management.
Key Features to Look for:
- Regulatory Compliance – The software must be Part 11 compliant with the electronic signatures and secure audit trails.
- Integration – Ability to connect with LIMS, quality management systems, or laboratory instruments.
- User-Friendly Interface – Simplified dashboards encourage adoption by microbiologists and operators.
- Real-Time Monitoring – Alerts and trend analysis enable proactive responses before deviations escalate.
- Scalability – The system should handle data from multiple sites and cleanroom grades.
Cloud vs. On-Premises
Cloud-based EM software offers flexibility and reduced IT burden, while on-premises systems give companies more control over data security. The choice depends on organizational policy and regulatory expectations.
Vendor Evaluation
Software is only as good as its implementation support. Ask vendors about installation timelines, user training, and 24/7 technical support. A robust service-level agreement (SLA) is essential.
Balancing Cost, Compliance & Long-Term Value
While cost will always be a factor in vendor selection, it should never overshadow compliance and quality. A slightly more expensive vendor who provides reliable supply, validated products, and strong regulatory documentation is a better long-term partner than a cheaper supplier who causes audit observations.
Think of vendor selection not as a transaction but as a strategic partnership. The best vendors become part of your compliance ecosystem, helping you navigate regulatory inspections and reduce risks.
Future Trends In EM Vendor Offerings
The EM industry is evolving rapidly. Some trends buyers should watch out for include:
- Rapid Microbiological Methods (RMM): Faster microbial detection technologies reducing incubation time.
- Automated Air Samplers: Integration with IoT for real-time contamination alerts.
- Digital Twin Models: Predictive software that simulates cleanroom contamination patterns.
- Green & Sustainable Media: Vendors exploring eco-friendly packaging and recyclable plastics.
Forward-looking companies should choose vendors investing in these innovations, ensuring their monitoring programs remain future-ready.
To dive deeper into the importance of regulatory guidelines in EM, cTo dive deeper into the importance of regulatory guidelines in EM, check out our article on Investigations into EM Excursions in Sterile AreasTo dive deeper into the importance of regulatory guidelines in EM, check out our article on Investigations into EM Excursions in Sterile Areasheck out our article on Investigations into EM Excursions in Sterile AreasTo dive deeper into the importance of regulatory guidelines in EM, check out our article on Investigations into EM Excursions in Sterile Areas
Conclusion
Choosing the right EM vendors, media, samplers, and software is a decision that directly impacts both product quality and patient safety. To dive deeper into the importance of regulatory guidelines in EM, check out our article on Investigations into EM Excursions in Sterile Areas.
In the pharmaceutical microbiology industry, where regulatory scrutiny is intense and the margin for error is nonexistent, vendor selection must go beyond price comparisons.
A strong partner will provide validated products, reliable supply chains, technical expertise, and compliant digital solutions. By carefully evaluating vendors on compliance, performance, service, and innovation, pharmaceutical manufacturers can build a robust environmental monitoring program that not only meets today’s regulatory requirements but also adapts to tomorrow’s challenges.
A systematic approach to designing an environmental monitoring program ensures vendor integration aligns with site-specific risk and frequency mapping.
In the end, your EM program is only as strong as the vendors behind it. Choose wisely, and you secure not just compliance, but also trust, reliability, and long-term operational excellence.
FAQs
Q1. Why is vendor selection critical in pharmaceutical environmental monitoring?
Because unreliable media, samplers, or software can compromise compliance, risk contamination, and threaten patient safety. Vendors are part of your compliance ecosystem.
Q2. What factors should I consider when choosing EM vendors?
Check for regulatory compliance, validated products, supply chain reliability, technical support, customization options, and both global + local presence.
Q3. How do I choose the right microbial air sampler for cleanrooms?
Evaluate sampler type (impaction vs. liquid), airflow rate, portability, ease of cleaning, reproducibility, and vendor calibration/maintenance support.
Q4. What features should EM compliance software include?
Look for 21 CFR Part 11 compliance, secure audit trails, real-time alerts, scalability, integration with LIMS/QMS, and strong vendor technical support.
Q5. Should cost or compliance matter more when choosing EM vendors?
Compliance and reliability should come first. A slightly higher-cost vendor with validated, GMP-compliant products is safer than a cheaper one risking regulatory findings.





